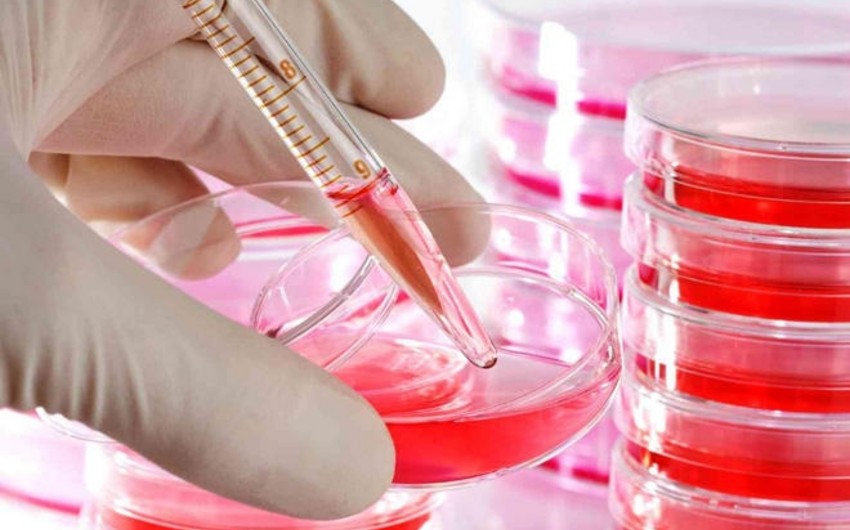

Ötən altı ay ərzində Azərbaycanda 736 nəfər İİV-ə (İnsanın immunçatışmazlığı virusu) yoluxub.
Bu barədə Narkomanlığa və Narkotik Vasitələrin Qanunsuz Dövriyyəsinə Qarşı Mübarizə üzrə Dövlət Komissiyasının daimi fəaliyyət göstərən İşçi Qrupu məlumat yayıb.
Qeyd olunub ki, Respublika QİÇS-lə Mübarizə Mərkəzinin verdiyi məlumata əsasən ölkədə narkomanların İnsanın İmmunçatışmazlığı Virusuna yeni yoluxma hadisələrinin sayında azalma müşahidə olunur.
Belə ki, ötən 6 ay ərzində İİV-ə 736 nəfər yoluxub. Onlardan 723 nəfəri Azərbaycan vətəndaşı, 13 nəfəri isə əcnəbi olub. Azərbaycan vətəndaşları arasında 33 nəfəri (5,4%-i) inyekson narkotik istifadəçiləri olub.
.



